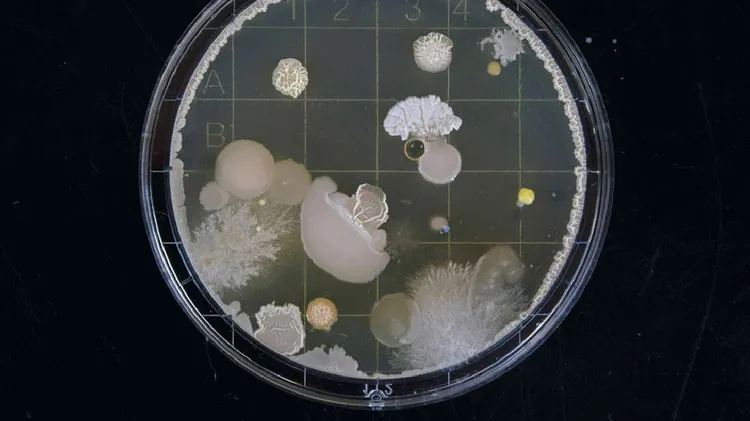

RUM
3 februari 2026
Genom att läsa RUM håller du dig uppdaterad om det senaste inom arkitektur, inredning och design. Tidningen strävar efter att ge en varierad och mångbottnad bild av arkitektur- och designvärlden och skriver om allt från unga formgivare och experimentell arkitektur till gamla kyrkor och stormarknader!
...Läs mer